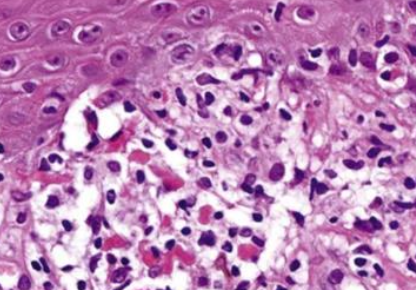
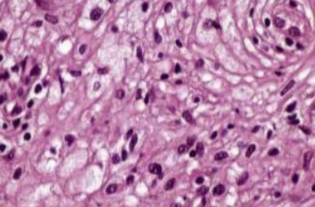

皮膚疾病
外胚層發育不良
- Ectodermal Dysplasia
- 兩個以上外胚層來源的構造無
- X隱性
- EDA mutation
- NFκB family
- 特徵
- 缺牙、少髮、口乾、無汗
- 完全缺牙 (anodontia) 少見
- 眼睛周圍細小、有色素沉澱的皺紋
- midface hypoplasia
- 指甲可能出現營養不良和易碎

角化異常
Disorder of Keratinization
角質
5、14: 複層口腔上皮都有
1、6、10、16: 角化
4、13、19: 非角化
| 名稱 | 成因 | GLA | 特徵 | |||
|---|---|---|---|---|---|---|
| White Sponge Nevus良 (Cannon disease) |
體顯性 | 兩側的頰黏膜,出生時、孩童早期 |
|
|||
 |
||||||
| Hereditary Benign Intraepithelial Dyskeratosis良 (HBID, Witkop’s disease) |
體顯性 GENE: 4q35端粒, NLRP1, M77T |
口腔與結膜黏膜,孩童 |
 |
|||
 |
||||||
| Dyskeratosis Congenita 先天性角化不良 |
X隱性 GENE: DKC1 |
10y ↓ |
 |
|||
|
||||||
| Hereditary Mucoepithelial Dysplasia良 | 體顯性 | - |
|
|||
  |
||||||
過度角化
| 名稱 | 成因 | GLA | 特徵 | |||
|---|---|---|---|---|---|---|
| Pachyonychia Congenita 先天性厚甲症 | 體顯性 | - |
  |
|||
|
||||||
 |
||||||
| Papillon-Lefèvre Syndrome | GENE: cathepsin C gene |
手掌與腳底 |
|
|||
 |
||||||
色素相關
| 名稱 | 成因 | GLA | 特徵 | |||
|---|---|---|---|---|---|---|
| Xeroderma Pigmentosum罕 著色性乾皮病 |
體隱性,UV損傷修復不能 | 下唇和舌尖(SCC 多), 很早 (口腔: 20y↓ ; 非黑色素皮膚癌: 10y↓) |
|
|||
| Peutz-Jeghers syndrome | 體顯性, 抑癌 GENE: STK11(LKB1) |
兒童早期 |
   |
|||
| Incontinentia Pigmenti (色素失調病,Bloch-Sulzberger syndrome ) |
X顯性 GENE: NEMO (NFκB Essential Modulator) |
剛出生 |
|
|||
水皰期上皮內裂解,內部充滿嗜酸性球疣狀期過度角化, acanthosis, papillomatosis色素過度沉積階段皮下結締組織 melanin-containing macrophage,即黑色素失調(melanin incontinence) |
||||||
Hair Follicle & Sebaceous glands
| 名稱 | 成因 | GLA | 特徵 | |||
|---|---|---|---|---|---|---|
| Cowden Syndrome (多發性缺陷瘤症候群,Multiple hamartoma syndrome) |
GENE: PTEN (腫瘤抑制,20% 測不到) |
  |
||||
| Muir-Torre Syndrome | DNA mismatch repair 異常, GENE: MSH2(90%), MLH1 |
50-60y, AIDS |
 |
|||
  |
||||||
上皮裂解
Acantholytic Disorder
| 名稱 | 成因 | GLA | 特徵 | |||
|---|---|---|---|---|---|---|
| Keratosis follicularis (Darier Disease) | 體顯性, ATP2A2 mutation → 細胞內鈣離子幫浦(SERCA2) 異常 → desmosome 異常 | 10-20y |
    |
|||
  |
||||||
| Warty Dyskeratoma (疣狀角化不良, Isolated Darier disease) |
- |
|
|
|||
| Pemphigus 天疱瘡 |
自體免疫疾病 | |||||
| vulgaris (PV,常見) | Ab 打 Desmosomes | 50y |
|
|||
 |
||||||
| Paraneoplastic Pemphigus罕 (PP) 腫瘤誘導性天疱瘡 |
|
   |
||||
 |
||||||
- Nikolsky sign
- 水泡邊緣摸一摸,給一個側方力量,水泡會越來越大
皮下裂解
Subepidermal Blistering Disease
泡泡龍寶寶
| 名稱 | 成因 | GLA | 特徵 | |||
|---|---|---|---|---|---|---|
| Epidermolysis Bullosa (大泡性表皮鬆解,泡泡龍寶寶) |
細胞附著蛋白異常 → 異質性遺傳性皮黏膜水皰病變 | |||||
| Simplex | keratin 5, 14 | 上皮內裂,輕微 | ||||
| Junctional |
|
|
||||
| Dystrophic type | collagen 7 | Dominant (體顯性)
Generalized Recessive (全身隱性)
|
||||
| Kindler syndrome | hemidesmosomal attachment protein, kindlin-1 |
基底細胞層下方與透明層的界面處裂解  |
||||
| Epidermolysis bullosa acquisita (EBA) |
|
手背 |
  |
|||
 |
||||||
| Angina Bullosa Hemorrhagica | 創傷、類固醇相關 | 軟顎,中年 |
 |
|||
類天皰瘡
| 名稱 | 成因 | GLA | 特徵 | |||
|---|---|---|---|---|---|---|
| Mucous Membrane Pemphigoid (黏膜類天皰瘡, Cicatricial pemphigoid,瘢痕性類天皰瘡) |
|
50-60y,口腔, 各式黏膜 |
  |
|||
 |
||||||
| Bullous Pemphigoid (BP) 大皰性類天疱瘡 |
|
75-80y |
|
|||
 |
||||||
| Linear IgA Bullous Disease (LAD) 線狀 IgA 大皰性皮膚病 |
|
青少年, 老人 |
   |
|||
| Dermatitis Herpetiformis (DH) 疱疹性皮膚炎 |
|
青壯年和中年人 |
|
|||
   |
||||||
hemidesmosome
epiligrin = laminin-5 = laminin-332
type XVII collagen = BP180
type VII collagen = BP290


苔蘚樣皮膚炎
Lichenoid and Interface Dermatitis
- Basal cell 退化
| 名稱 | 成因 | GLA | 特徵 | |||
|---|---|---|---|---|---|---|
| Lichen Planus (LP) 扁平苔癬 |
壓力、甲狀腺低落? | 中年,口腔黏膜單發 |
|
|||
無症狀 網狀型 (Reticular form )
丘疹型 (Papular type)
斑塊型 (Plaque type)
  有症狀 Erosive
 Bullous form
Ulcerative form
|
||||||
|
||||||
| Lichenoid Contact Reaction | amalgam (半抗原) | LP,但只出現在有 amalgam 的位置、移除 amalgam 即消失。 | ||||
| Lichenoid Drug Reaction | 藥物 | 非直接性 IgG 螢光染色 → string of pearls (沿著複層鱗狀上皮的 basal cell layer 細胞膜)  |
||||
| Chronic Ulcerative Stomatitis (CUS) 慢性潰瘍性口炎 |
自體免疫: p63 的異構體 | 60y |
   |
|||
| Graft-Versus-Host Disease (GVHD) | 骨髓移植 | 舌頭、唇頰側黏膜 |
|
|||
 |
||||||
| Erythema Multiforme (EM) 多形性紅斑 |
HSV, 肺炎黴漿菌 (Mycoplasma pneumoniae) 相關 | 20-30y, 黏膜(口腔) |
    |
|||
  |
||||||
| EM minor | 只有皮膚,雙側對稱 |
|
||||
| Stevens-Johnson Syndrome |
|
年輕 |
   |
|||
 |
||||||
| Toxic Epidermal Necrolysis | 60y ↑ |
|
||||
Lupus Erythematosus (LE) 紅斑性狼瘡
-
B lymphocyte ↑,T lymphocyte 功能不正常
- typeIII 過敏 , 抗體打抗體
-
女性多
-
血檢
- ANAs+
- Sm antibody+ (30%,高特異)
- dsDNA antibody+
| 名稱 | GLA | 特徵 | |||
|---|---|---|---|---|---|
| 系統性紅斑狼瘡 (SLE) | 31y |
   |
|||
| Chronic cutaneous (CCLE) | 侷限在皮膚、黏膜表面 |
 |
|||
| Subacute cutaneous (SCLE) | - |
 |
|||
組織
-
慢性發炎浸潤
-
Basal layer 退化
-
Basal membrane IgM、IgG 或 C3 沈積
-
皮膚
- 上皮
- 萎縮且扁平,偶有 acanthosis
- Basal membrane 增厚
- PAS 染色證明
- 上皮


- 口腔
- 過度角化 → 白線
- Basal membrane 斑塊 (PAS +)
- 上皮下、深層血管周圍淋巴細胞浸潤


牛皮癬皮膚炎
Psoriasiform Dermatitis
| 名稱 | 成因 | GLA | 特徵 | |||
|---|---|---|---|---|---|---|
| Psoriasis 牛皮癬 |
|
20-30y,頭皮、手肘和膝蓋 |
  |
|||
  |
||||||
| Erythema Migrans良 游移性紅斑,地圖舌 |
都沒啥相關 | 多到少:
|
  |
|||
| Reactive Arthritis (RA) 反應性關節炎 |
可能有免疫介導 | - |
 |
|||
Collagen and Elastic Tissue
| 名稱 | 成因 | GLA | 特徵 | |||
|---|---|---|---|---|---|---|
| Ehlers-Danlos Syndrome | 體顯性 (80%) Type V collagen GENE: COL5A1, COL5A2 |
- | Classical type
|
|||
Hypermobility type
|
||||||
Vascular/ ecchymotic type
|
||||||
type VIII罕
|
||||||
| Marfan’s syndrome | GENE: FBN1 (fibrillin-1,肌原纖維,影響 Collagen) |
- |
|
|||
| Tuberous Sclerosis (結節型硬化症, Epilolianuria) |
體顯性, GENE: TSC1, TSC2 |
- |

  
|
|||
  |
||||||
| Proteus syndrome | GENE: AKT1 (PKB related) |
- |
 |
|||
特發性結締組織疾病
Idiopathic Connective Tissue Disorders
| 名稱 | 成因 | GLA | 特徵 | |||
|---|---|---|---|---|---|---|
| Systemic Sclerosis 全身性硬化 |
M2 macrophage 相關 | 成年 |
  |
|||
 |
||||||
 |
||||||
| localized scleroderma | 類似 Systemic Sclerosis, 但指影響一塊局部皮膚,無後遺症 | |||||
| CREST Syndrome | 一種 Scleroderma 變形 | 50-60y |
|
|||
缺鐵性貧血相關病症
- MCV/RBC
- 缺鐵性貧血: >16
- 地中海型貧血: <13
- 口腔灼熱感、口角炎(angular cheilitis)
- 廣泛性口腔黏膜萎縮(generalized oral mucosal atrophy)
- 萎縮性舌炎(atrophic glossitis): 一片光滑
| 名稱 | 成因 | GLA | 特徵 | |||
|---|---|---|---|---|---|---|
| Hereditary Hemorrhagic Telangiectasia (遺傳性出血性微血管擴張症,HHT,Weber syndrome) | 體顯性,GENE
|
|
||||
| Plummer-Vinson syndrom罕 | - | 30-50y |
  |
|||
退化性、代謝性疾病
Degenerative and Metabolic Diseases
| 名稱 | 成因 | GLA | 特徵 | |||
|---|---|---|---|---|---|---|
| Acanthosis Nigricans 黑色棘皮層增厚病 |
良性 |
|
||||
| 惡性 |
  |
|||||
|
||||||
| Xanthelasma 黃斑瘤 |
血脂升高 | 中老年,眼周圍 |
|
|||
血管疾病
Vascular Diseases
| 名稱 | 成因 | GLA | 特徵 | |||
|---|---|---|---|---|---|---|
| Behçet Syndrome |
|
30-40y,眼部、口腔、生殖器和皮膚 |
   |
|||
  |
||||||
| MAGIC syndrome | Behçet syndrome 變形。多發性的口腔與生殖器潰瘍,間質性的軟骨炎 (Mouth and Genital Ulcers with Inflamed Cartilage Syndrome ) |
|||||
| Aphthous Ulcer 口瘡性潰瘍 |
CD8+ T cell 破壞上皮 | 30y↓, 非角化上皮 |
   |
|||
| Kawasaki Disease 川崎氏病 |
- | 10y↓亞裔 |
|
|||
其他
- X隱性
- 外胚層發育不良
- Dyskeratosis Congenita
- X顯性
- Incontinentia Pigmenti (色素失調病,Bloch-Sulzberger syndrome )
- NEMO
- Incontinentia Pigmenti (色素失調病,Bloch-Sulzberger syndrome )
- 舌背白斑
- Lichen planus
- Pachyonychia Congenita
- Dyskeratosis congenita
- 脫屑性牙齦炎
- MMP, LP, PV
- 易有惡性變化
- Dyskeratosis Congenita (OPMD)
- Xeroderma Pigmentosum (SCC, BCC)
- GVHD (SCC)
- Generalized Recessive Dystrophic EB (SCC)
- Plummer-Vinson syndrom (SCC)
- Peutz-Jeghers syndrome (胃腸道腺癌, 乳癌)
- Cowden Syndrome ( 乳腺癌risk)
- DNA repair 異常
- Muir-Torre Syndrome
- Keratoacanthoma
- Xeroderma Pigmentosum
指甲

舌頭
- Hairy Tongue 是絲狀乳頭過度角化,與抽菸相關。
- Fissure Tongue 是絲狀乳頭角化消失。
- Hairy Leukoplakia 較常在舌側,與其他三者不同。[EBV 感染]

天疱瘡們

裂開
- Acantholytic
- PV
- Darier Disease
牙齒 Hemidesmosomes 無 17 → MMP 口內病灶常見
| 目標 | EB | Pemphigus |
|---|---|---|
| Hemidesmosomes | ||
| Keratin 5,14 | Simplex | - |
| BP230 | - | BP |
| Collagen 17 (BP180) | Junctional | BP, LAD |
| Laminin-332 | MMP | |
| α6β5 integrin | MMP (α6) | |
| Collagen 7 (BP290) | Dystrophic, EBA | - |
| Desmosomes | ||
| Desmoglein 1,3 | - | PV, PP |
| Plakin family | - | PP |


復發性口瘡
